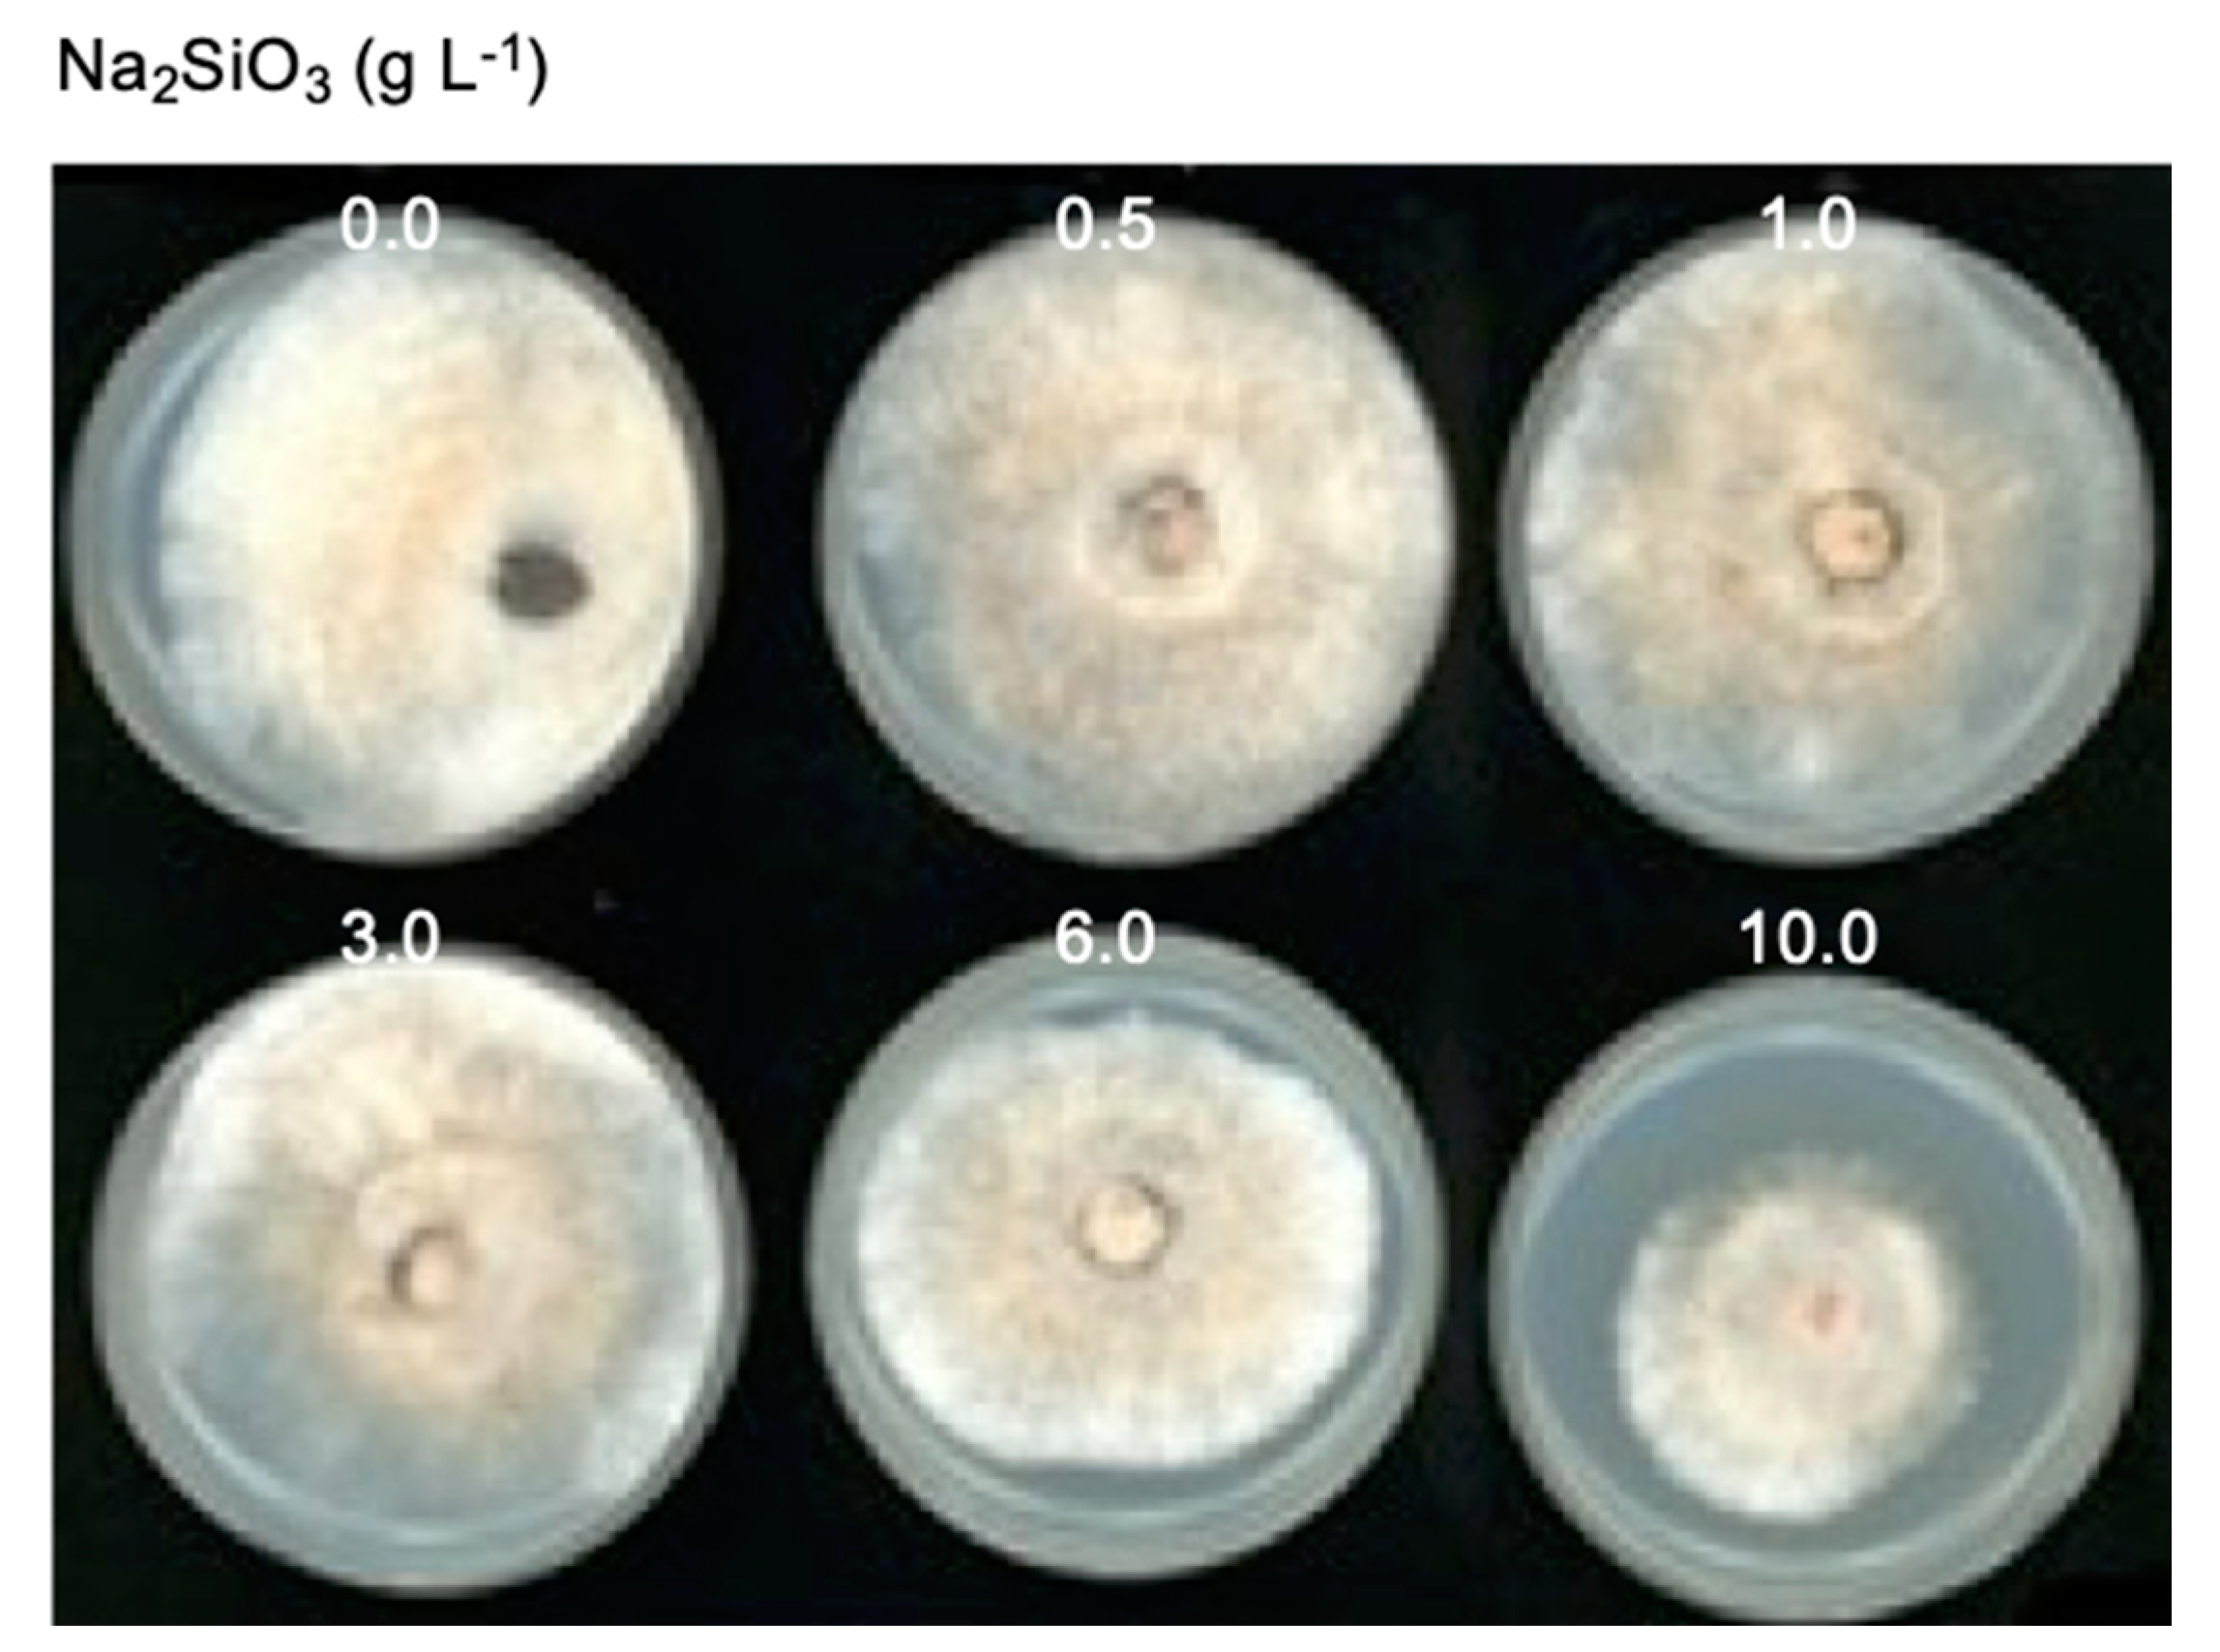
Agronomy 11 00899 g006

Silicon Enhances Resistance to Red Crown Rot Caused by Calonectria ilicicola in Soybean
Abstract
1. Introduction
2. Materials and Methods
2.1. Plant Growth Conditions and Si Application
2.2. Pathogen Culture and Inoculation
2.3. Measurement of Disease Severity and Relative Fungal Growth
2.4. Measurement of Plant Growth Parameters
2.5. Measurement of Leaf Relative Water Content (RWC)
2.6. Determination of Si and N Content
2.7. Assessment of the Effects of Si on Fungal Growth
2.8. Measurement of Malondialdehyde (MDA) Concentration
2.9. Statistical Analyses
3. Results
3.1. Effect of Si Application on RCR Development in the Roots
3.2. Correlation Analysis of Si Uptake and C. ilicicola Infection Parameters
3.3. Effect of Si Application on Growth of Infected Plants
3.4. Effect of Si Application on Seed Yield
3.5. Effect of Si on the Growth of C. ilicicola
4. Discussion
5. Conclusions
Author Contributions
Funding
Institutional Review Board Statement
Informed Consent Statement
Data Availability Statement
Acknowledgments
Conflicts of Interest
References
- Bel, D.; Sobers, E.K. A peg, pod, and root necrosis of peanuts caused by a species of Calonectria. Phytopathology 1966, 56, 1361–1364. [Google Scholar]
- Crous, P.; Wingfield, M.; Alfenas, A. Cylindrocladium parasiticum sp. nov., a new name for C. crotalariae. Mycol. Res. 1993, 97, 889–896. [Google Scholar] [CrossRef]
- Padgett, G.B.; Kuruppu, P.U.; Russin, J.S. Red crown rot. In Compendium of Soybean Diseases and Pest; Artman, G.L., Rupe, J.C., Sikora, E.J., Domier, L.L., Davis, J.A., Steffey, K.L., Eds.; The American Phytopathological Society Press: St. Paul, MN, USA, 2015; pp. 79–80. [Google Scholar]
- Guan, M.; Pan, R.; Gao, X.; Xu, D.; Deng, Q.; Deng, M. First report of red crown rot caused by Cylindrocladium parasiticum on soybean in Guangdong, Southern China. Plant Dis. 2010, 94, 485. [Google Scholar] [CrossRef]
- Tazawa, J.; Takahashi, M.; Usuki, K.; Yamamoto, H. Nodulation during vegetative growth of soybean stage does not affect the susceptibility to red crown rot caused by Calonectria ilicicola. J. Gen. Plant Pathol. 2007, 73, 180–184. [Google Scholar] [CrossRef]
- Nishi, K. Calonectria ilicicola, the causal pathogen of soybean red crown rot. MAFF Microorg. Genet. Resour. Man. No.21 Jpn. Engl. Summ. 2007, 1–13. [Google Scholar]
- Ochi, S. Studies on the epidemiology and control of red crown rot of soybean. J. Gen. Plant Pathol. 2017, 83, 427–428. [Google Scholar] [CrossRef]
- Sugimoto, T.; Kato, M.; Yoshida, S.; Matsumoto, I.; Kobayashi, T.; Kaga, A.; Hajika, M.; Yamamoto, R.; Watanabe, K.; Aino, M.; et al. Pathogenic diversity of Phytophthora sojae and breeding strategies to develop Phytophthora-resistant soybeans. Breed. Sci. 2012, 61, 511–522. [Google Scholar] [CrossRef] [PubMed]
- Bajgain, R.; Kawasaki, Y.; Akamatsu, Y.; Tanaka, Y.; Kawamura, H.; Katsura, K.; Shiraiwa, T. Biomass production and yield of soybean grown under converted paddy fields with excess water during the early growth stage. Field Crop. Res. 2015, 180, 221–227. [Google Scholar] [CrossRef]
- Kleczewski, N.; Plewa, D.; Kangas, C.; Phillippi, E.; Kleczewski, V. First report of red crown rot of Soybeans caused by Calonectria ilicicola (Anamorph: Cylindrocladium parasiticum) in Illinois. Plant Dis. 2019, 103, 1777. [Google Scholar] [CrossRef]
- Roy, K.W.; McLean, K.S.; Lawrence, G.W.; Patel, M.V.; Moore, W.F. First Report of Red Crown Rot on Soybeans in Mississippi. Plant Dis. 1989, 73, 273. [Google Scholar] [CrossRef]
- Jiang, C.J.; Sugano, S.; Ochi, S.; Kaga, A.; Ishimoto, M. Evaluation of Glycine max and Glycine soja for Resistance to Calonectria ilicicola. Agronomy 2020, 10, 887. [Google Scholar] [CrossRef]
- Datnoff, L.E.; Deren, C.W.; Snyder, G.H. Silicon fertilization for disease management of rice in Florida. Crop Protect. 1997, 16, 525–531. [Google Scholar] [CrossRef]
- Datnoff, L.E.; Rodrigues, F.A.; Seebold, K. Silicon and Plant Disease; APS Press: St. Paul, MN, USA, 2007; pp. 233–246. [Google Scholar]
- Cai, K.Z.; Gao, D.; Luo, S.M.; Zeng, R.S.; Yang, J.Y.; Zhu, X.Y. Physiological and cytological mechanisms of silicon-induced resistance in rice against blast disease. Physiol. Plant. 2008, 134, 324–333. [Google Scholar] [CrossRef] [PubMed]
- Debona, D.; Rodrigues, F.A.; Datnoff, L.E. Silicon’s role in abiotic and biotic plant stresses. Annu. Rev. Phytopathol. 2017, 55, 85–107. [Google Scholar] [CrossRef]
- Fauteux, F.; Remus-Borel, W.; Menzies, J.G.; Belanger, R.R. Silicon and plant disease resistance against pathogenic fungi. FEMS Microbiol. Lett. 2005, 249, 1–6. [Google Scholar] [CrossRef] [PubMed]
- Wang, M.; Gao, L.M.; Dong, S.Y.; Sun, Y.M.; Shen, Q.R.; Guo, S.W. Role of Silicon on Plant-Pathogen Interactions. Front. Plant Sci. 2017, 8, 701. [Google Scholar] [CrossRef] [PubMed]
- Heine, G.; Tikum, G.; Horst, W.J. The effect of silicon on the infection by and spread of Pythium aphanidermatum in single roots of tomato and bitter gourd. J. Exp. Bot. 2007, 58, 569–577. [Google Scholar] [CrossRef] [PubMed]
- Putra, R.; Powell, J.R.; Hartley, S.E.; Johnson, S.N. Is it time to include legumes in plant silicon research? Funct. Ecol. 2020, 34, 1142–1157. [Google Scholar] [CrossRef]
- Nolla, A.; Korndörfer, G.H.; Coelho, L. Efficiency of calcium silicate and carbonate in soybean disease control. J. Plant Nutr. 2006, 29, 2049–2061. [Google Scholar] [CrossRef]
- Rasoolizadeh, A.; Labbe, C.; Sonah, H.; Deshmukh, R.K.; Belzile, F.; Menzies, J.G.; Belanger, R.R. Silicon protects soybean plants against Phytophthora sojae by interfering with effector-receptor expression. BMC Plant Biol. 2018, 18, 1–13. [Google Scholar] [CrossRef]
- Guérin, V.; Lebreton, A.; Cogliati, E.E.; Hartley, S.E.; Belzile, F.; Menzies, J.G.; Bélanger, R.R. A zoospore inoculation method with Phytophthora sojae to assess the prophylactic role of silicon on soybean cultivars. Plant Dis. 2014, 98, 1632–1638. [Google Scholar] [CrossRef] [PubMed]
- Telles Nascimento, K.J.; Debona, D.; Silveira, P.R.; Silva, L.C.; DaMatta, F.M.; Rodrigues, F.Á. Silicon-induced changes in the antioxidant system reduce soybean resistance to frogeye leaf spot. J. Phytopathol. 2016, 164, 768–778. [Google Scholar] [CrossRef]
- Nascimento, K.J.T.; Debona, D.; França, S.K.S.; Gonçalves, M.G.M.; DaMatta, F.M.; Rodrigues, F.Á. Soybean resistance to Cercospora sojina infection is reduced by silicon. Phytopathology 2014, 104, 1183–1191. [Google Scholar] [CrossRef] [PubMed]
- Arsenault-Labrecque, G.; Menzies, J.G.; Bélanger, R.R. Effect of silicon absorption on soybean resistance to Phakopsora pachyrhizi in different cultivars. Plant Dis. 2012, 96, 37–42. [Google Scholar] [CrossRef]
- Cruz, M.F.A.; Rodrigues, F.Á.; Diniz, A.P.C.; Alves Moreira, M.; Barros, E.G. Soybean resistance to Phakopsora pachyrhizi as affected by acibenzolar-S-methyl, jasmonic acid and silicon. J. Phytopathol. 2014, 162, 133–136. [Google Scholar] [CrossRef]
- Nishi, K.; Sato, F.; Karasawa, T.; Sato, T.; Takahashi, H.; Nishi, K. (1999). Ecology and control of root necrosis of soybean caused by Calonectria crotalariae (Jpn. with English summary). Bull. Nat. Agric. Res. Cent. 1999, 30, 11–109. [Google Scholar]
- Ochi, S.; Kuroda, T. Developing a qPCR assay for the quantification of Calonectria ilicicola in soil of soybean field. Trop. Plant Pathol. 2020, 46, 186–194. [Google Scholar] [CrossRef]
- Sugano, S.; Sugimoto, T.; Takatsuji, H.; Jiang, C.J. Induction of resistance to Phytophthora sojae in soyabean (Glycine max) by salicylic acid and ethylene. Plant Pathol. 2013, 62, 1048–1056. [Google Scholar] [CrossRef]
- Filella, I.; Llusia, J.; Pinol, J.; Penuelas, J. Leaf gas exchange and fluorescence of Phillyrea latifolia, Pistacia lentiscus and Quercus ilex saplings in severe drought and high temperature conditions. Environ. Exp. Bot. 1998, 39, 213–220. [Google Scholar] [CrossRef]
- Elliott, C.L.; Snyder, G.H. Autoclave-Induced Digestion for the Colorimetric Determination of Silicon in Rice Straw. J. Agric. Food Chem. 1991, 39, 1118–1119. [Google Scholar] [CrossRef]
- Corbineau, F.; Gay-Mathieu, C.; Vinel, D.; Come, D. Decrease in sunflower (Helianthus annuus) seed viability caused by high temperature as related to energy metabolism, membrane damage and lipid composition. Physiol. Plant. 2002, 116, 489–496. [Google Scholar] [CrossRef]
- Akamatsu, H.; Fujii, N.; Saito, T.; Sayama, A.; Matsuda, H.; Kato, M.; Kowada, R.; Yasuta, Y.; Igarashi, Y.; Komori, H. Factors affecting red crown rot caused by Calonectria ilicicola in soybean cultivation. J. Gen. Plant Pathol. 2020, 86, 363–375. [Google Scholar] [CrossRef]
- Yamamoto, R.; Nakagawa, A.; Shimada, S.; Komatsu, S.; Kanematsu, S. Histopathology of red crown rot of soybean. J. Gen. Plant Pathol. 2017, 83, 23–32. [Google Scholar] [CrossRef]

| Source of Variation | df | p-Values | |||||
|---|---|---|---|---|---|---|---|
| Plant Height | Leaf Area | Shoot FW | Root FW | Shoot DW | DS | ||
| Silicon (Si) concentration | 4 | 0.0001 | 0.0002 | 0.0000 | 0.0000 | 0.0003 | 0.0000 |
| Sampling time point (T) | 1 | 0.0000 | 0.0000 | 0.0000 | 0.0000 | 0.0000 | 0.0024 |
| Si × T | 4 | 0.0250 | 0.0025 | 0.0016 | 0.0027 | 0.0034 | 0.0041 |
| Treatments (Na2SiO3 g L−1) | Percent Inhibition | ||
|---|---|---|---|
| 4 Days | 10 Days | 14 Days | |
| 0.5 | −2.25 | −2.89 | −3.89 |
| 1 | 2.01 | 7.27 | 0.00 |
| 3 | 10.10 | 8.17 | 0.00 |
| 6 | 32.22 | 18.19 | 12.45 |
| 10 | 79.23 | 67.88 | 57.25 |
| ANOVA | p-value | ||
| Source of variation | 4 days | 10 days | 14 days |
| Si concentration | 0.0000 | 0.0001 | 0.00001 |
Publisher’s Note: MDPI stays neutral with regard to jurisdictional claims in published maps and institutional affiliations. |
© 2021 by the authors. Licensee MDPI, Basel, Switzerland. This article is an open access article distributed under the terms and conditions of the Creative Commons Attribution (CC BY) license (https://creativecommons.org/licenses/by/4.0/).
Share and Cite
Win, K.T.; Maeda, S.; Kobayashi, M.; Jiang, C.-J. Silicon Enhances Resistance to Red Crown Rot Caused by Calonectria ilicicola in Soybean. Agronomy 2021, 11, 899. https://doi.org/10.3390/agronomy11050899
Win KT, Maeda S, Kobayashi M, Jiang C-J. Silicon Enhances Resistance to Red Crown Rot Caused by Calonectria ilicicola in Soybean. Agronomy. 2021; 11(5):899. https://doi.org/10.3390/agronomy11050899
Chicago/Turabian StyleWin, Khin Thuzar, Satoru Maeda, Michie Kobayashi, and Chang-Jie Jiang. 2021. "Silicon Enhances Resistance to Red Crown Rot Caused by Calonectria ilicicola in Soybean" Agronomy 11, no. 5: 899. https://doi.org/10.3390/agronomy11050899
APA StyleWin, K. T., Maeda, S., Kobayashi, M., & Jiang, C.-J. (2021). Silicon Enhances Resistance to Red Crown Rot Caused by Calonectria ilicicola in Soybean. Agronomy, 11(5), 899. https://doi.org/10.3390/agronomy11050899

